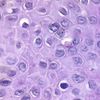

pathology repro Flashcards
(112 cards)
1
Q

A
POI
2
Q

A
Penis histology
3
Q

A
penis histology
4
Q

A
Epispadias & hipospadias
5
Q

A
Chordee
6
Q

A
Scrotal engulfment (penoscrotal transposition)
7
Q

A
Phimosis
8
Q

A
Paraphymosis
9
Q

A
Penile lichen sclerosous
10
Q

A
Balantis Xerotica obliterans
11
Q

A
Condilomata acuminata
12
Q

A
Syphyllis
13
Q

A
Chancroid
14
Q

A
Peyronie
15
Q

A
Penile in situ carcinoma
16
Q
A
Bowen’s disease (in situ carci)
17
Q

A
Bowenoid papulosis
18
Q

A
Erithroplasia of queyrat
19
Q

A
Erithroplasia of queyrat
20
Q

A
Carcinoma of penis
21
Q

A
normal breast histo
22
Q

A
acute mastitis
23
Q

A
Fat necrosis
24
Q

A
epitheleal hyperplasia
25

Sclerosing adenosis
26

coplex sclerosing lesion
27

papiloma
28

profilelative lesions with atypia
29

profilelative lesions with atypia
30

fibroadenoma
31

fibroadenoma
32

fibroadenoma
33

fibroadenoma
34

Phyllodes tumor
35

Phyllodes tumor
36

Phyllodes tumor
37

Phyllodes tumor
38

serous epithelileal tumor
39

serous epithelileal tumor, cystis linned epithelium,
40

mucinous epidermoid
41

brenner tumor
42

teratoma
43

dysgerminoma
44

granulosa cell tumors (call-exner bodies)
45

metastic tumor
46

normal endometrium
47

three phases
48

congenital anomalies
49

endometriosis
50

endometroisis
51

endometroisis
52

endometroisis
53

endometroisis
54

endometroisis
55

uterine hyperplasia
56

simple without atypia
57

complex without atypia
58

simple with atypia
59

complex with atypia
60

leiomyoma
61

leiomyoma
62

leiomyoma
63

uterine leiomyoma
64

ovary
65

ovary
66

ectopic pregnancy
67

ectopic pregnancy
68

ectopic pregnancy
69

normal placenta
70

creta's
71

acute necrotizing villositis
72

preclampsia
73

hydatidiform mole
74

hydatidiform mole
75

complete hydatidiform mole
76

hydatidiform mole
toe like extensions
extravillous thropho striking nuclear atypia
cyto-syncytiothropho
77

snow flakes
hydatidiform mole
78

invasive mole
79

normal prostate
80

normal prostate
81

chronic prostate
82

prostatic abscess
83

prostatic abscess
84

FGF
TGT-B
85

Benign prostate hyperplasia
86

normal prostate histo
87

BPH
88

bph
89

normal vaginal histo
90

congenital anomalies
91

congenital anomalies
92

imperforate hymen
hematocolops
fibrous hymen
93

herpes simplex
94

molluscum contagiosum
95

molluscum contagiosum histo
96

condyloma acuminatum
97

Candida albicans
Fungals infection
98

Candida albicans
Fungals infection
99

Trichomonas vaginalis
Parasite infections
Strawberry cervix
100

101

Gardnerella gavinalis
Bacterial infection
102

Gardnerella gavinalis
Bacterial infection
103

PID
104

PID COMPLICATION
Fitz hugh curtis
105

bartholian cyst
106

endocervical polyps
107

Endocervical polyp histo
108

cervical intraepithelial neoplasia
109

profilerative lesions with atypia
110

types of breast caner
111

classification
112